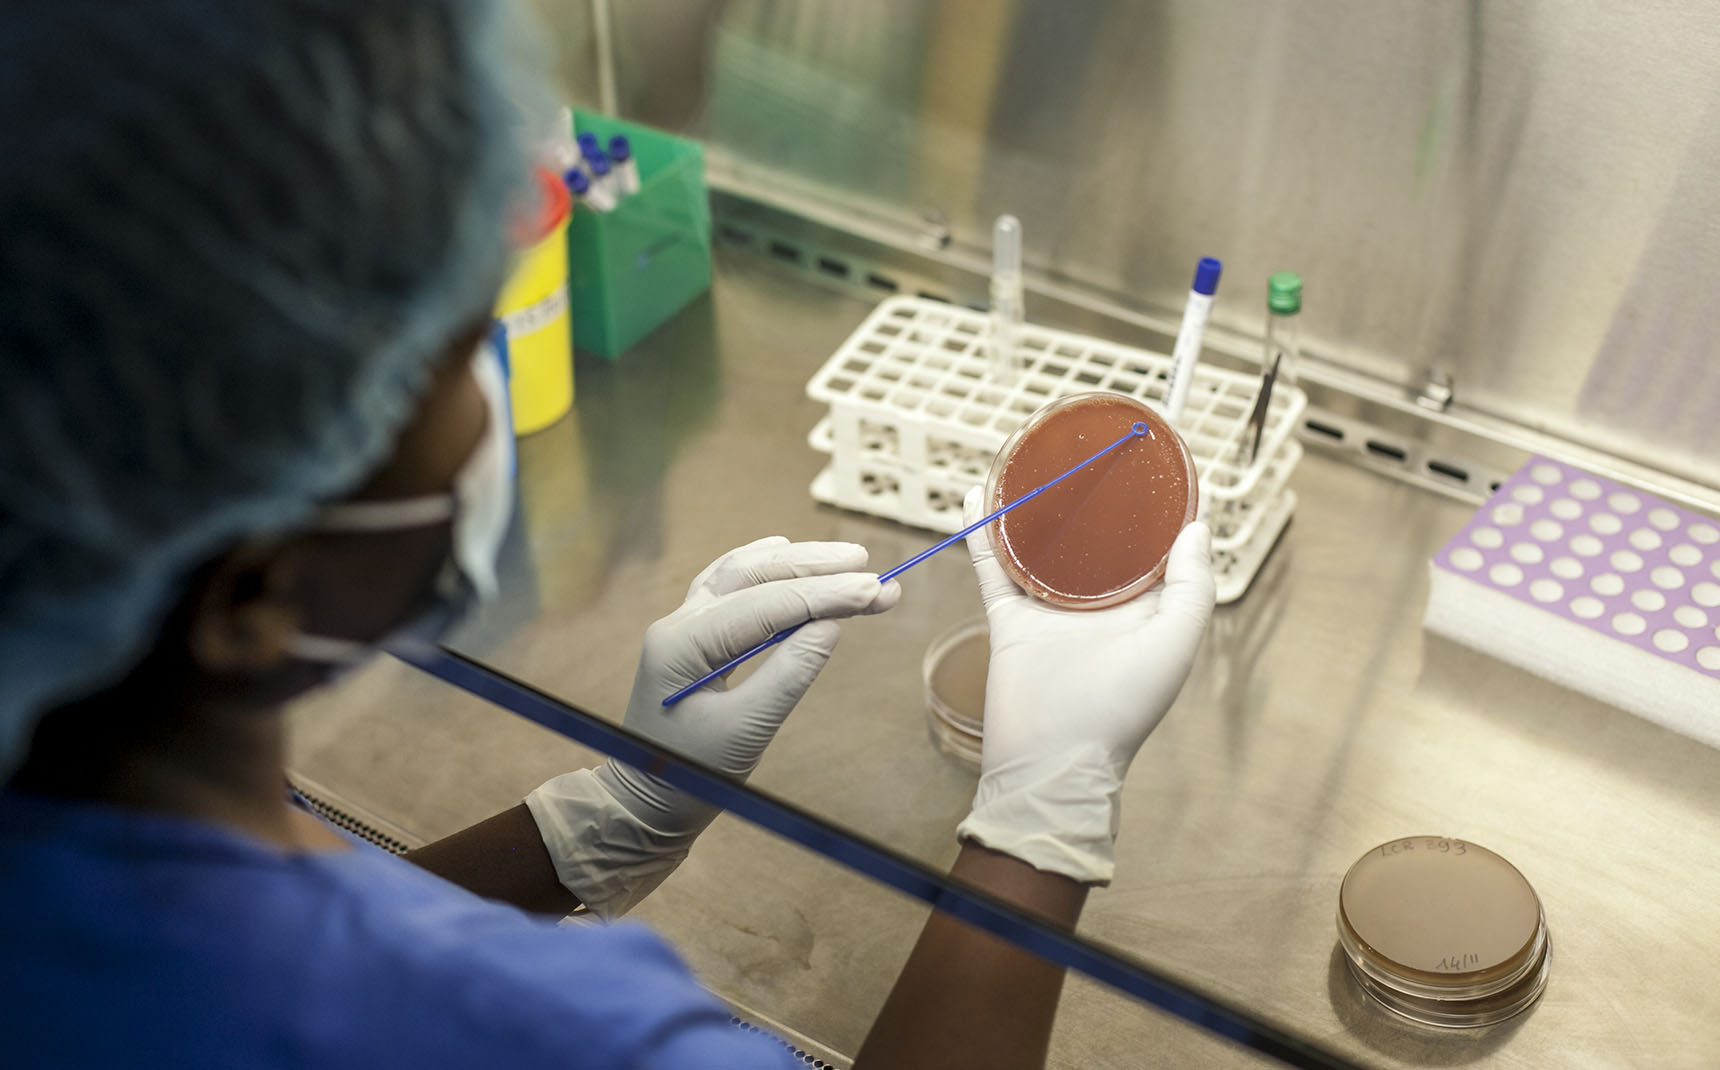
Vu du dessus, un laborantin porte une charlotte, une blouse bleue et des gants blancs et manipule une boite de pétri rose.

Nos priorités
La Fondation Mérieux intervient à l’international contre les maladies infectieuses les plus meurtrières, telles que la tuberculose et les infections respiratoires aiguës. Elle fait de la lutte contre la résistance aux antimicrobiens une priorité, et se mobilise également sur les pathogènes émergents et réémergents.
Déjà liée à 1,14 million de décès chaque année, la résistance aux antimicrobiens (RAM) s’accélère depuis les années 2000. Selon l’Organisation mondiale de la Santé, elle est l’une des dix plus grandes menaces pour la santé publique auxquelles l’humanité est confrontée.

L’usage excessif ou inapproprié des antibiotiques et autres antimicrobiens favorise le développement d’agents pathogènes résistants aux médicaments. Ses conséquences dévastatrices mettent à mal des siècles d’avancées médicales. Apparition de maladies plus longues et plus difficiles à traiter, renchérissement des traitements ou encore augmentation des risques lors d’interventions médicales jusqu’alors routinières sont en passe de se généraliser.
Parce que la résistance aux antimicrobiens est un phénomène global affectant tout le vivant, lutter contre elle nécessite une approche pluridisciplinaire. Adoptant une approche One Health (« Une seule santé »), la Fondation Mérieux initie et participe à de nombreux projets de surveillance collaboratifs destinés à mieux comprendre son évolution et à identifier des moyens de la freiner. Sur le terrain, nous contribuons au renforcement des capacités diagnostiques des laboratoires et à leur mise en réseaux aux échelles nationale et internationale. En les rendant capables d’effectuer des examens de culture et de sensibilité aux antibiotiques, ces réseaux de laboratoires permettent une meilleure prise en charge des patients et de générer des données essentielles pour la surveillance de la résistance aux antimicrobiens. Nous menons également des actions de formation au bon usage des antibiotiques auprès des cliniciens.
Ces différentes actions améliorent la collecte de données et documentent ainsi l’impact des plans de riposte des politiques de santé nationales. En renforçant les capacités des acteurs de la santé et en appuyant les pays dans la conception de leurs plans d’action, nous œuvrons pour des systèmes de santé plus forts et résilients face à la menace de la résistance aux antimicrobiens.
décès sont imputables à la résistance aux antimicrobiens chaque année
En 2050, ce chiffre pourrait atteindre
de décès